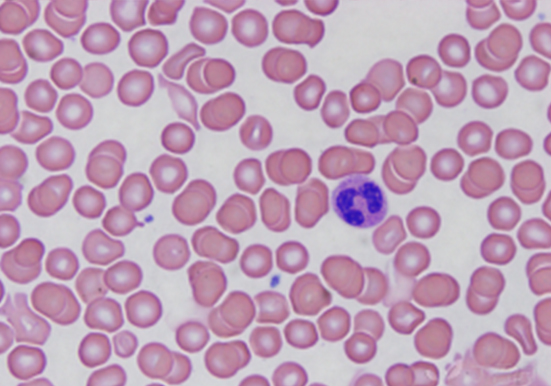

服务详情
以下是关于瑞士吉姆萨染色的详细介绍:
基本原理
吉姆萨染液由天青、伊红等成分组成。其染色原理基于细胞内不同物质的酸碱性质差异。细胞内的嗜酸性物质,如碱性蛋白质,与酸性染料伊红结合,染成粉红色;嗜碱性物质,如细胞核蛋白和淋巴细胞胞浆,与碱性染料美蓝或天青结合,显紫蓝色;中性颗粒呈等电状态,与伊红和美蓝均可结合,染淡紫色。
染色步骤
标本固定:在涂片上加甲醇数滴,约 30 秒后将甲醇振去,空气干燥,或将标本放在甲醇容器中,浸泡固定 1-5 分钟。
染色:将新配的吉姆萨应用液 2-3 毫升加在标本上,静置 15-30 分钟。
冲洗:使标本保持原来的水平位置,从一侧缓缓注入自来水,使染料从标本的另一侧冲去,以避免染料沉淀。
干燥与镜检:把标本斜置在滤纸上,待干后镜检